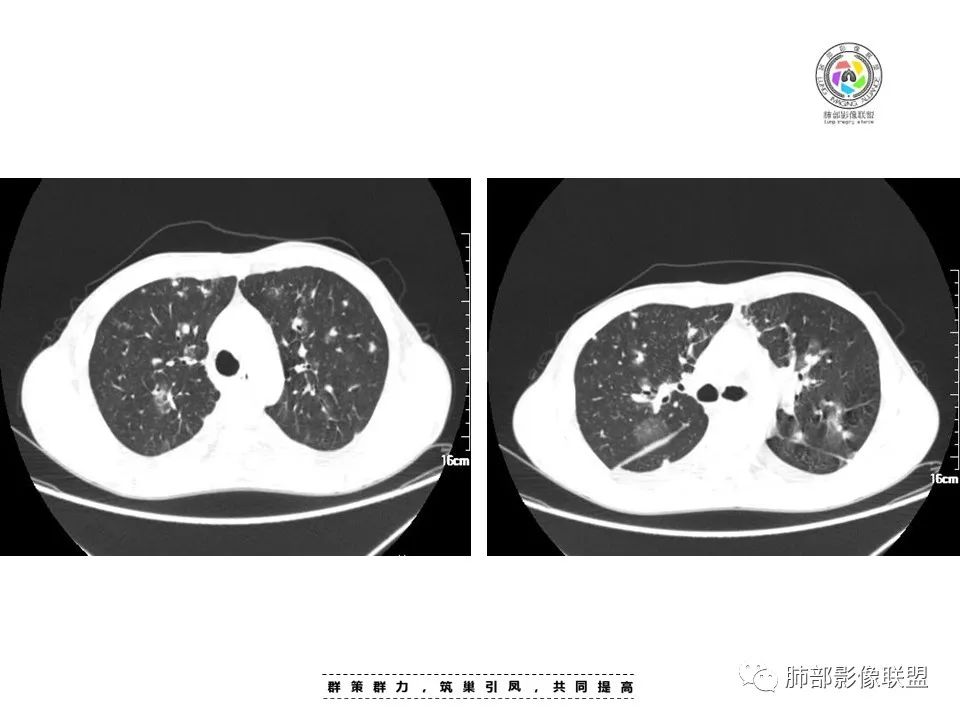
【病例】HIV卡波西肉瘤1例肺部影像表现-6
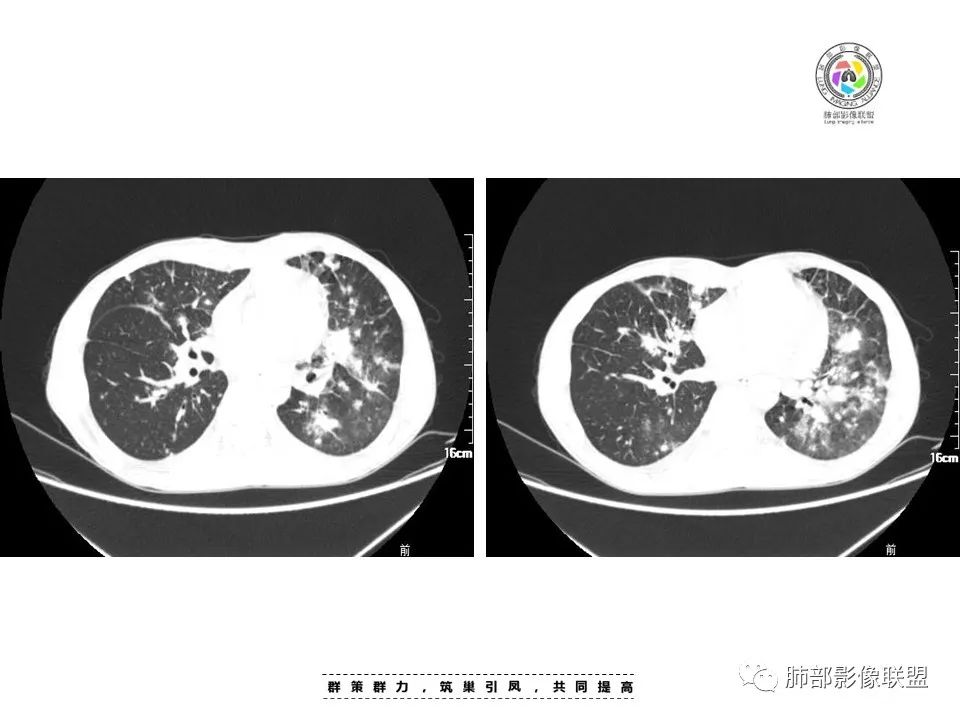
【病例】HIV卡波西肉瘤1例肺部影像表现-8

HIV卡波西肉瘤1例肺部影像表现
发布时间:2022-10-14
发布时间:2022-10-14

一切∮随缘:双肺多发大小不等结节,部分融合实变,以双下肺明显,部分延血管束走形,支气管壁增厚、扩张,临床:男性,45岁,发热,伴有皮疹,考虑马尔尼菲青霉菌,鉴别曲霉,念珠菌。
许慧良:
中年男人患者,发热纳差,乏力伴皮疹1月,体温38.4℃,全身暗紫色丘疹,CD4明显降低,双肺多发斑片结节影,周围伴有晕征,有沿支气管血管束分布趋势,无坏死,无空洞,淋巴结增大不明显,考虑机会性感染性病变,马尔尼菲篮状菌病?结核?鉴别淋巴瘤,血管炎(GPA)。
go and see:
多发结节,肿块,边缘可见晕征,向心性分布,胸膜下病变轻,总体还是气道分布的病变
离殇??:
中年男性,发热、纳差、乏力、皮疹1月,,全身散在暗紫色丘疹,CD4明显减少,双肺散在多发斑片状、结节状密度增高影,边缘稍模糊,以双肺下叶较多,沿支气管血管束播散征象,小叶间隔增厚,叶间裂及双重胸膜腔少量积液,考虑马尼可能大,建议真菌,比如曲霉?念珠菌等
放射小白:
周一晚读病例:男性45岁,发热、纳差,全身散在暗紫色皮疹,结合CD4,符合HIV;肺部影像表现:两肺散在实性结节及磨玻璃密度影,实性结节伴晕征,部分沿支气管血管束分布,支气管血管束增粗,以两肺下叶为著,类似火焰征,双侧胸腔少量积液;首先考虑卡波西肉瘤,鉴别淋巴瘤增值性病变,淋巴瘤样肉芽肿/淋巴瘤,最后挂上马尔尼菲青霉菌病。
wj:
马尼,和淋巴瘤
间质分布;淋巴,网织内皮细胞
joyzhy:
中年男性发热并皮疹,实验室检查CD4减低,白细胞低,提示免疫缺陷。影像双肺结节、结片,沿支气管血管束向心性肺部,下肺重,合并双肺门及纵隔7区淋巴结肿大。结片周围有晕样磨玻璃显示。诊断1:机会感染,免疫缺陷、发热、皮疹,机会感染需要考虑,广西马儿地方病多有淋巴道结节考虑、隐球菌,疱疹病毒可以有磨玻璃晕,但分布隐球菌多胸膜下、疱疹病毒少融合,二者放待排。2:肿瘤性病变,淋巴瘤、长期发热、双肺门淋巴结肿大、肺门淋巴道结节,需要考虑。其次双肺转移性病变,也不能排除,但肿瘤标志物多正常,放大待排, 最后 1.马儿>淋巴瘤>真菌、病毒及转移
go and see:
CD4极低,有皮疹,首先还是要考虑马尼。
若晗:
男性!皮疹十发热十免疫下降十双肺大小结节及斑片影!首先考虑马尼!鉴别淋巴瘤
谢加平:
两肺多形态小斑片影,上轻下重沿支气管血管分布,双肺下叶小片状,密度不均匀,含模糊的GGO影,右肺中、下叶与左肺舌叶及下叶病灶累及中轴及小叶间隔增厚,双肺叶间胸膜增厚及伴随粟粒结节,双侧胸腔对称性少量积液,纵隔脂肪间隙混浊(示淋巴回流受阻),慢性发病,发热,乏力,皮肤皮诊表现,贪血,WBC,CD4+低,脾增大,肺感染疾病:马尔尼菲篮状菌,并发TB待排,支气管镜肺泡灌洗液和结核X-Pert检查。
AAA张春雨:
HIV合并马尔尼菲青霉菌感染
go and see:
鉴别:HIV相关性恶性肿瘤
AAA张春雨:
CD4和CD8是人体免疫力的两项重要指标,代表CD4细胞和CD8细胞的数值,均属于T淋巴细胞,而CD4也是HIV的受体。二者在人体免疫功能发挥中均具有重要作用,其数值变化及比值也常被作为艾滋病感染患者病情进展依据,以及自身免疫疾病的诊断参考依据。
一、下降:
1、CD4下降:若患者同时伴有CD3的下降,则通常与恶性肿瘤、艾滋病以及应用免疫抑制剂的情况有关,如果下降幅度较大时,需要积极进行治疗;
2、CD8下降:若患者同时伴有CD3下降,则可能提示存在自身免疫性疾病;
3、CD4与CD8比值下降:通常提示存在艾滋病、其他恶性肿瘤以及病毒感染等情况,艾滋病病毒进入人体后,通常会对以CDO细胞为代表的靶细胞造成损害,这时患者会出现CD4数量的大幅下降,作为病毒入侵的提示信号。CD8细胞可抵抗和消灭入侵的病毒,故而当CD4细胞受损并发出信号的病毒,故而当CD4细胞受损并发出信号提示时,CD8细胞的数量会大幅增加以抵抗病毒,保护机体。CD4与CD8的比值通常在1.4-2.0,而病毒入侵时则会出现CD4细胞数量下降,而CD8细胞数量的增加,导致二者比值下降。但随病情进一步发展 CD8数值也会逐渐降低,二者比值关系不再作为参考依据,也不具临床意义。
不吝慷慨:
这个人CD4特别低,考虑有艾滋?双肺感染,真菌感染?马尼考虑吗
go and see:
感染性病变与HIV相关性恶性肿瘤鉴别,注意排除卡波西
AAA张春雨:
当然,卡波西肉瘤和结核也不能除外,尤其部分病灶似火焰状,虽然不是全部。
不吝慷慨:
艾滋病除了合并PCP,结核和马尼也很多见
涂涂万金油`:
累及皮肤:马,奴,鼻。暗紫,应该是马
洪桥爱:
中年男性,发热、全身散在暗紫色丘疹,查CD4+T细胞64个/ul,临床信息提示AIDS并发卡波西肉瘤;CT提示双肺多发实性结节影及毛玻璃结节,部分呈点晕征,右上肺大姐姐边缘膨隆、分叶伴晕;双下肺结节沿支气管血管束分布,中轴间质增粗,部分支气管堵塞,叶间裂结节状增厚,部分结节胸膜下分布,可疑局部小叶间隔增厚,肺部病变呈淋巴分布特点,结合临床肺部病变考虑肺卡波西肉瘤,鉴别淋巴瘤。
呼吸道分泌物念珠菌生长,临床意义待定,可能为定植菌污染,可查查血真菌培养,看有无念珠菌败血症可能,如血培养念珠生长,那就确诊侵袭性念珠菌病,当然血培养还有一个重点关注对象,马尔尼菲篮状菌,这个在AIDS患者里是当红明星,肺部病变也还不能完全排除马尼可能。
go and see:
卡波西也可以引起皮疹
AAA张春雨:
@Dr赖(鹤山人医pccm)?赖老师的情报如果可靠,那马尼可能性就上升到第一位,其次卡波西。
南边:
CD4这么低,间质为主
谢加平:
火焰征
采莲:
考虑马尔尼菲篮状菌
嘻嘻??:
首先考虑马尼,鉴别淋巴瘤哦
红星:
2022.8.29晚读:病例1
男,45岁
病史:发热、纳差、乏力、皮疹1月。T38.4℃,,全身散在暗紫色丘疹。CD8高,CD4低。CA-125略高。
两肺弥漫性性结节状、小片状及片状带晕的病灶,煎蛋征、点晕征,主要分布两肺中下叶,病灶周围小叶间隔增厚呈网格状影,部分病灶累及胸膜,伴两侧胸膜增厚。
印象:
真菌性肺炎,弥漫性病变,形态多样,混合晕征。
病毒性肺部感染,表现为肺部晕征及点晕改变。
血管炎:病灶累及下血管,肺泡及腺泡填充,周围渗出,代表出血,并累及气道。ANCA相关性的血管炎,包括GPA、MPA和EGPA,结合临床全身散在暗紫色丘疹,可以考虑。
肿瘤性病变:转移瘤?淋巴瘤?等
寄生虫肺部感染?
嘻嘻??:
卡波西的皮疹和马尼的皮疹各自有特征性?
go and see:
日常工作中看到脐凹的皮疹,首先会先考虑马尼
嘻嘻??:
马尼是脐凹的,也只见过网络图
王崇军:
有可能马是坑,我支持卡波西肉瘤
AAA张春雨:
艾滋病合并马尼和卡波西!
go and see:
卡波
王崇军:
暗紫色丘疹,不就是卡波的血管扩张吗
病例结果

病例点评
1.一般认为卡波西肉瘤与人类疱疹病毒8(HHV-8)以及乳头状瘤病毒感染密切相关。但感染HHV-8并不意味着就此罹患卡波西肉瘤,在免疫抑制或遗传等易感性患者,则卡波西肉瘤有可能接踵而至,如HIV的“助攻”……
2.本例双肺小叶间隔增厚明显,多发结节影及片状实性密度影,沿血管支气管束分布为主,两侧较为对称,病灶多环以磨玻璃晕,边界不清。
双侧胸腔少量积液。双肺门及纵隔未见明确肿大淋巴结,纵隔结构间隙模糊。
3.有学者将这种具有沿双肺支气管束分布的实性密度片影描述为“火焰征”,认为具有一定特征性,单就影像表现而言,这种影像表现也可以见于其他病损或多种病理改变的叠加。
如马尔尼菲篮状菌感染,HIV患者总会联想到它!同样可以出现双肺多发结节影、片影及磨玻璃影,结节影边界也可以较为清楚(甚至可以有点类似结核那种肉芽肿结节),磨玻璃影常见于灶周出血等等。尽管临床实践中马尔尼菲篮状菌感染似乎更多表现为淋巴增大及网质内皮系统损害(如肝脾改变)以及较特有的带有脐凹的皮疹等等。
4.患者病史发热、纳差、乏力、暗紫色皮疹一月,其中暗紫色皮疹对卡波西肉瘤的诊断具有一定提示意义。
知识汇总
一概述:卡波西肉瘤(Kaposis’s Sarcoma)又称Kaposi肉瘤、多发性特发性出血性肉瘤(multiple idiopathic hemorrhagic sarcoma)。1872年由Kaposi首次报道,是一种由淋巴或血管周围的细胞发展而来的恶性肿瘤。主要发生于免疫缺陷人群。通常表现为皮肤病变,但也可以发展到身体的其他部位,包括肺、淋巴结、消化系统。
较为明确的是与感染一种人类疱疹病毒8型(HHV-8)的病毒相关。
二分类:
分为四种类型:经典型、AIDS相关型、医源型和非洲型。
经典型KS一般起源于下肢远端(足部及小腿),表现为皮肤多发蓝色、紫色皮肤结节或破损;多合并淋巴组织肿瘤,淋巴结和胃肠道最易受累。
AIDS型KS皮肤结节分布无规律,临床表现多样,进展迅速,更多见于口腔黏膜,内脏器官,如淋巴结、肺、胃肠道等器官。

三病理:
KS的典型镜下表现为大量异型增殖的梭形细胞+血管样裂隙+红细胞外渗及含铁血黄素沉积。
免疫组化显示CD31、CD34阳性率较高;D2-40阳性,提示KS本质上是淋巴管性肿瘤。
四临床表现:
疼痛是最常见的临床表现,其次是淋巴结肿大、肿胀、瘙痒等。
五影像表现:
KS肺部影像表现:
1.结节型:两肺沿支气管血管束分布的结节影,呈火焰状或星芒状、挂果征,局部周围出血磨玻璃影(肺泡出血或水肿)。

2.支气管血管束增粗型:
肺门周围支气管壁呈“套袖样”改变。

3.肺炎渗出型:
斑片渗出影,部分融合呈“火焰样”,同时有火焰样结节,小叶间隔增厚等表现。
还可以有纵隔及腋下淋巴结增大,胸腔积液等表现。

六鉴别诊断:
[1]张岩岩,王杏,李宏军. 艾滋病合并肺部卡波西肉瘤的影像表现[J]. 中国艾滋病性病,2020,12:1336-1338.
[2]卢亦波,施裕新,刘晋新,等. 艾滋病合并卡波西肉瘤多脏器组织侵犯的影像学分析[J]. 新发传染病电子杂志,2020,01:8-15.
上一篇:前纵隔畸胎瘤2例CT影像